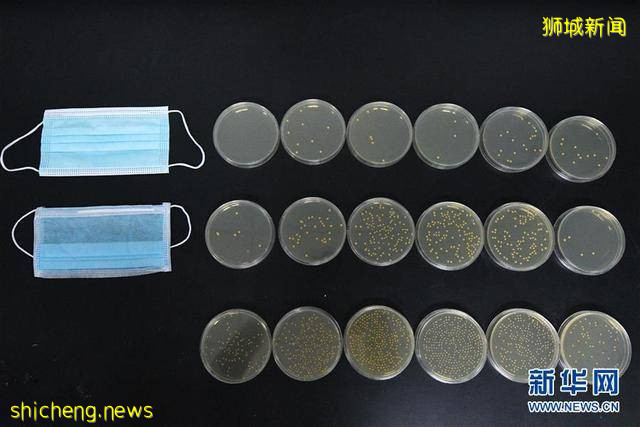
探访新加坡外科口罩检测实验室

探访新加坡外科口罩检测实验室
8月18日,新加坡实科检测公司的工作人员在实验室里对外科口罩进行细菌过滤效率检测。 新加坡实科检测公司提供ASTM标准(美国材料实验协会标准)的外科口罩检测服务,对口罩质量进行把关。 新华社发(邓智炜摄)

8月18日,新加坡实科检测公司的工作人员在实验室里对外科口罩进行细菌过滤效率检测。 新加坡实科检测公司提供ASTM标准(美国材料实验协会标准)的外科口罩检测服务,对口罩质量进行把关。 新华社发(邓智炜摄)
这是8月18日拍摄的新加坡实科检测公司实验室对口罩进行细菌过滤效率检测后的结果对比,上排为外科口罩检测结果,中排为普通口罩检测结果,下排为无口罩检测结果。 新加坡实科检测公司提供ASTM标准(美国材料实验协会标准)的外科口罩检测服务,对口罩质量进行把关。 新华社发(邓智炜摄)

8月18日,新加坡实科检测公司实验室对外科口罩进行阻燃性能测试。 新加坡实科检测公司提供ASTM标准(美国材料实验协会标准)的外科口罩检测服务,对口罩质量进行把关。 新华社发(邓智炜摄)

8月18日,新加坡实科检测公司实验室对外科口罩进行阻燃性能测试。 新加坡实科检测公司提供ASTM标准(美国材料实验协会标准)的外科口罩检测服务,对口罩质量进行把关。 新华社发(邓智炜摄)

8月18日,新加坡实科检测公司实验室对外科口罩进行阻燃性能测试。 新加坡实科检测公司提供ASTM标准(美国材料实验协会标准)的外科口罩检测服务,对口罩质量进行把关。 新华社发(邓智炜摄)

8月18日,新加坡实科检测公司的工作人员在实验室里对外科口罩进行合成血液穿透测试。 新加坡实科检测公司提供ASTM标准(美国材料实验协会标准)的外科口罩检测服务,对口罩质量进行把关。 新华社发(邓智炜摄)

8月18日,新加坡实科检测公司的工作人员在实验室里对外科口罩进行合成血液穿透测试。 新加坡实科检测公司提供ASTM标准(美国材料实验协会标准)的外科口罩检测服务,对口罩质量进行把关。 新华社发(邓智炜摄)
评论